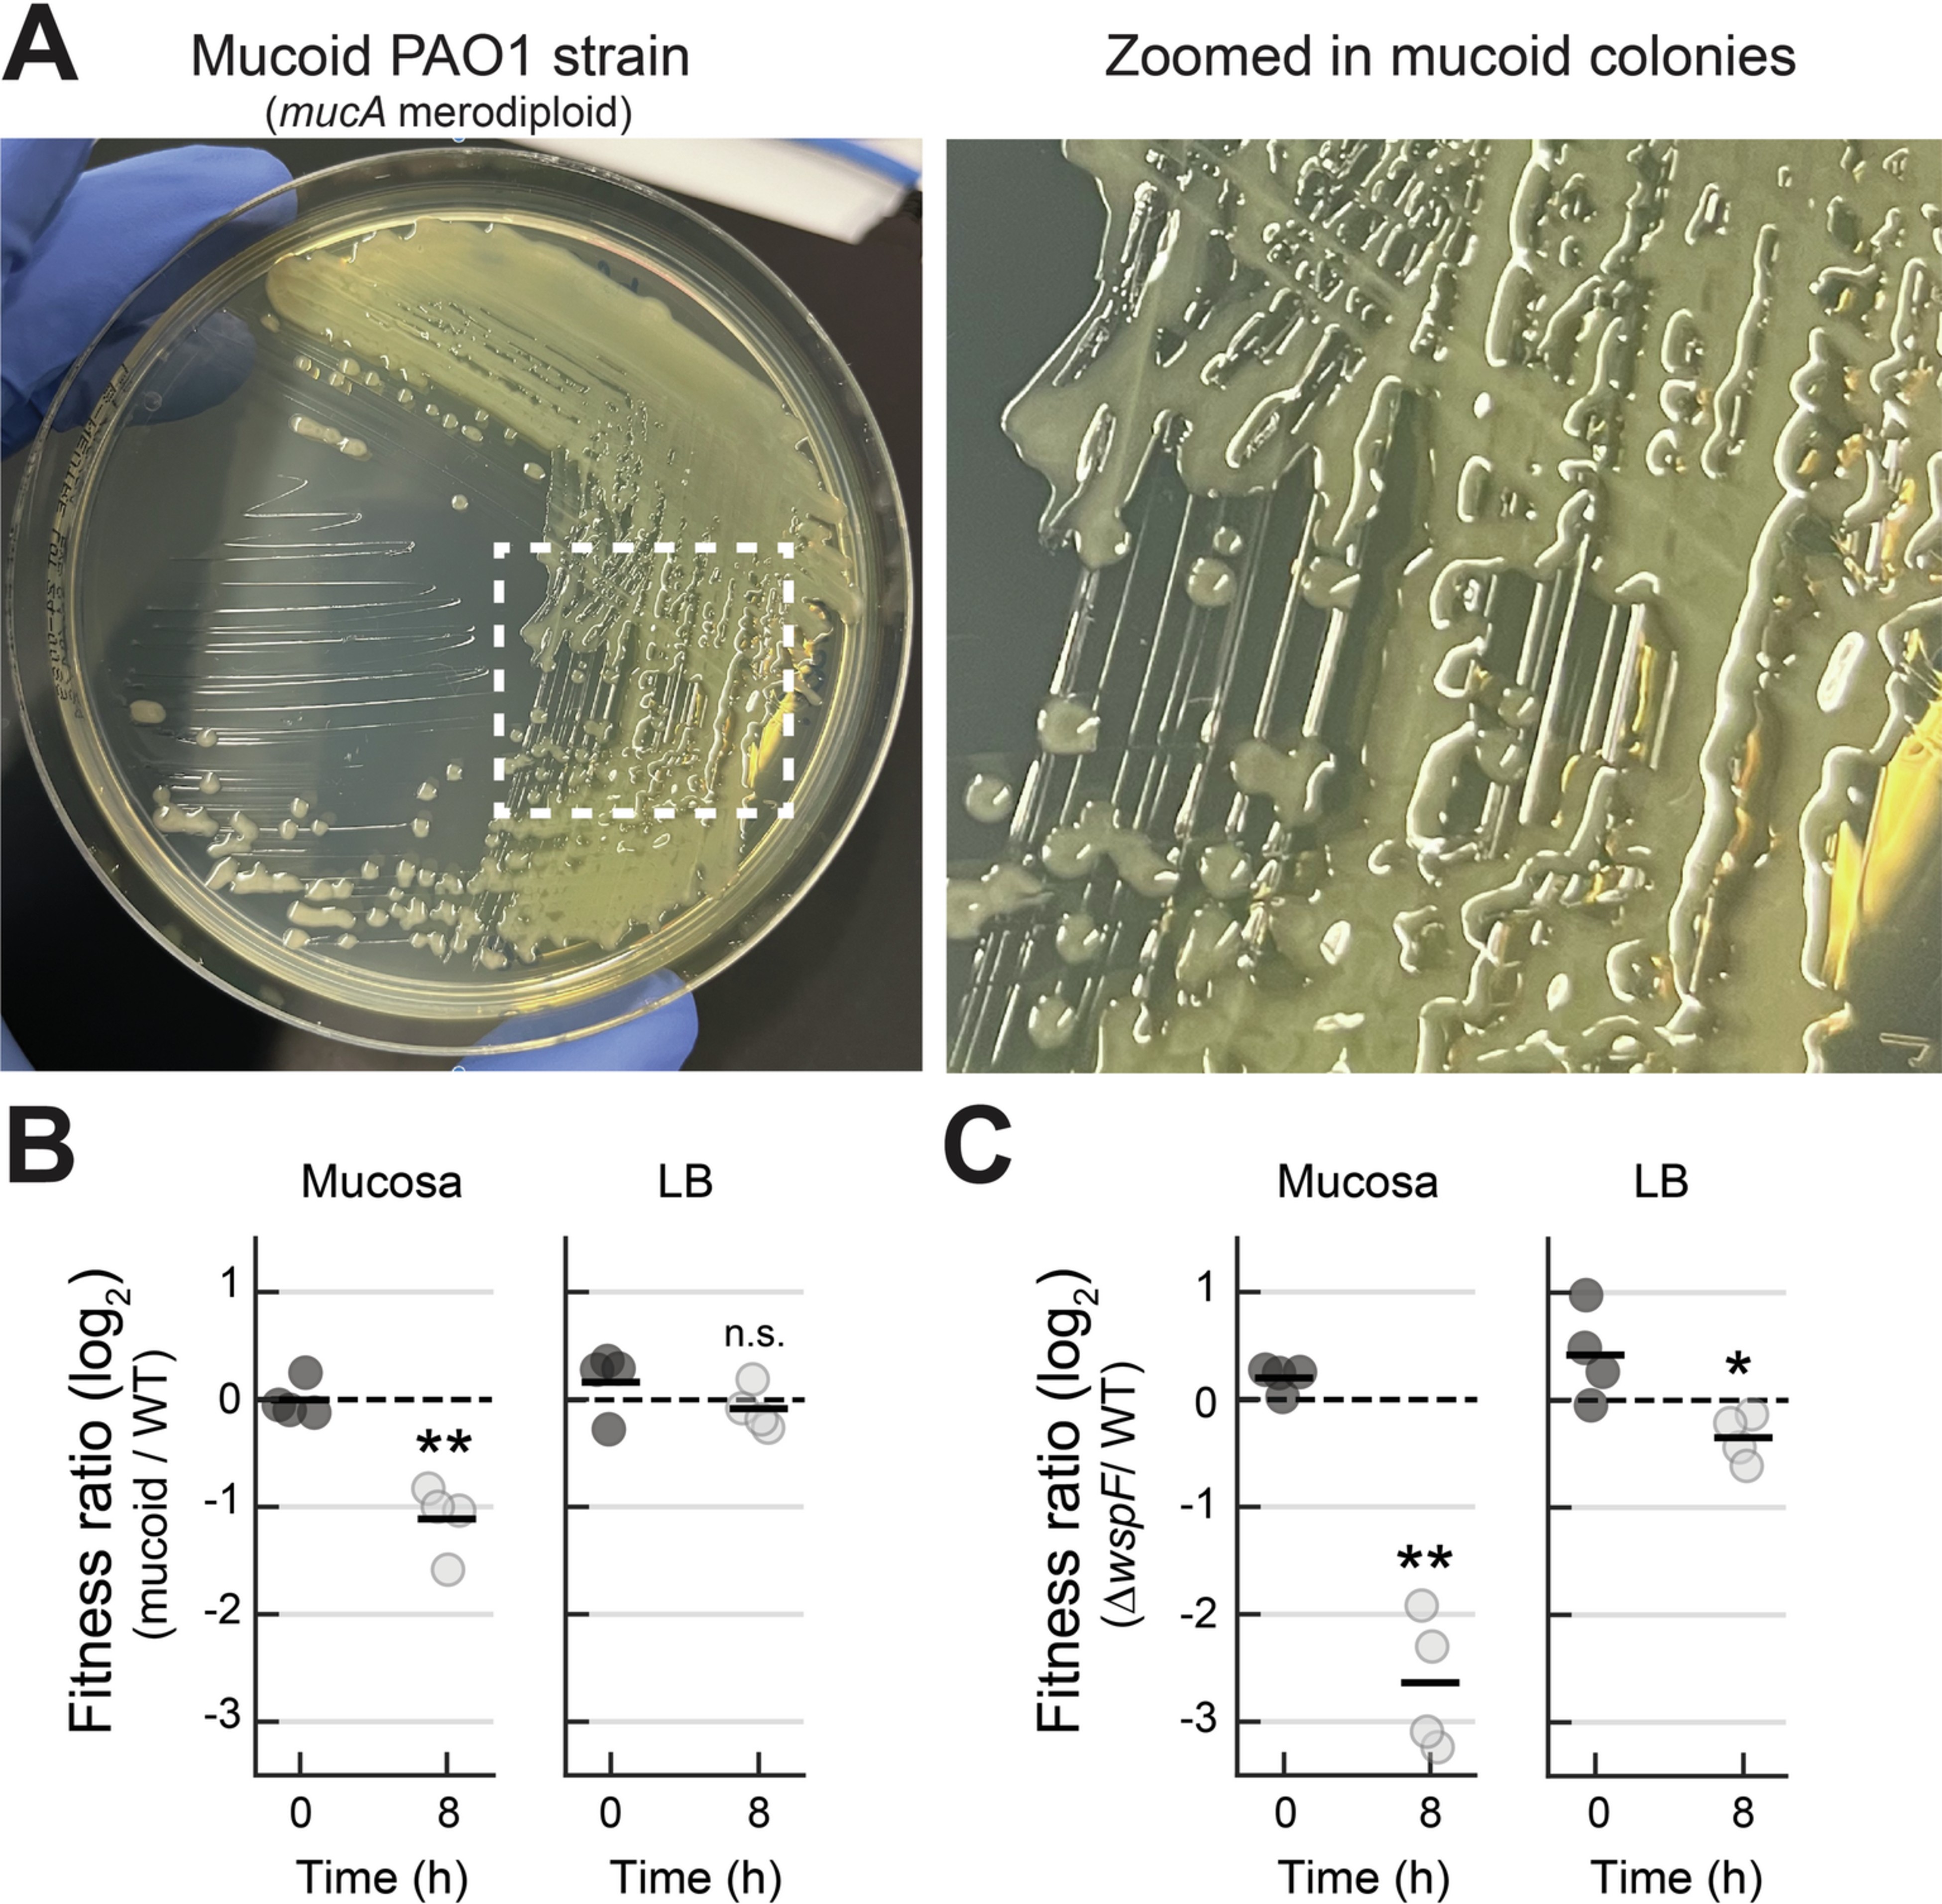
Extended Data Fig. 5

Extended Data Fig. 5: Competition between WT and an alginate overproducing strain (mucoid).
A. Pictures of the mucoid PAO1 strain, a mucA merodiploid. B. CFU-based validation of the fitness changes mediated by alginate overproduction. Competitions of WT and mucoid strain at the mucosa (left) and in LB (right). Each data point represents the CFUs ratio (mucoid divided by WT) of a single replicate (n = 4 for each condition). These ratios were calculated for the inoculum (0 h) and at the end of competition (8 h), for both conditions (mucosa vs LB). The horizontal black lines mark their mean. C. Fitness ratio of ∆wspF competed against WT, displayed for comparison. These ratios were calculated the same way using the CFU values shown in Fig. 3b. All experiments were performed with CF HBE cells. Statistics: panels B and C, Welch unpaired t-test (two-sided) (** p < 0.01, * p < 0.05, n.s. p > 0.05). Abbreviations: CFU, colony-forming units; LB, Luria-Bertani broth; WT, wild-type. The data underlying this figure and information on statistical analyses can be found in the source data available with this manuscript (see Data Availability session).
